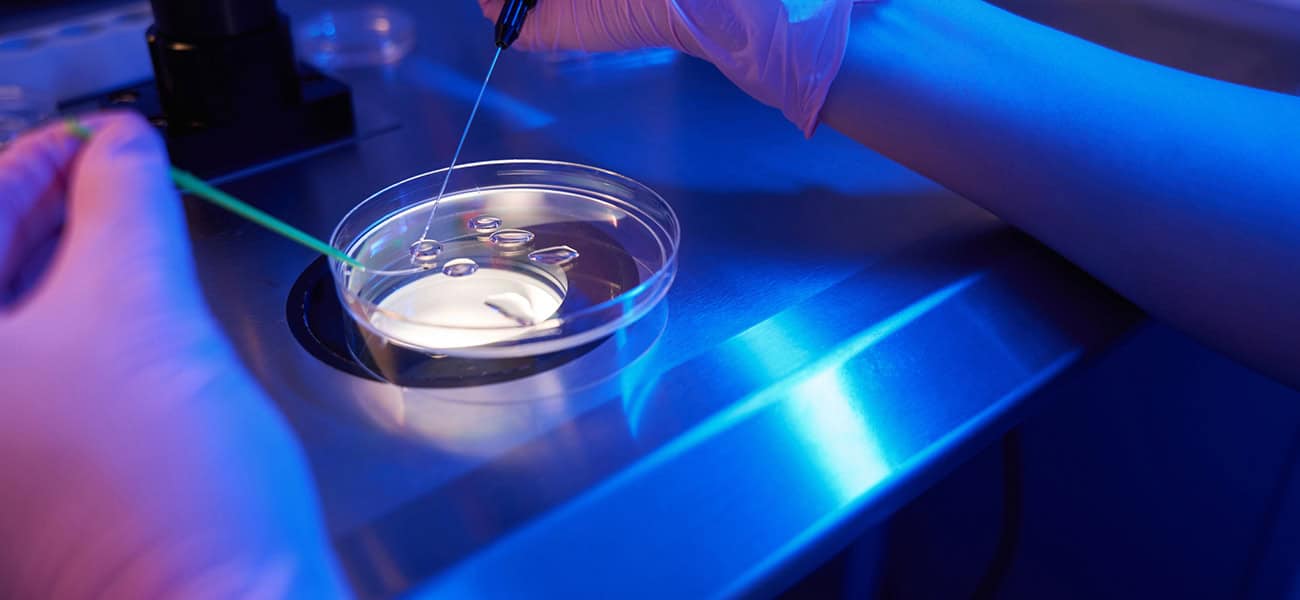

Abstract: This case study highlights the complex, multifactorial nature of recurrent implantation failure (RIF) in a young patient with a history of eight unsuccessful embryo transfers. It educates clinicians and embryologists on evidence-based strategies, potential diagnostic oversights, and treatment pathways that may improve implantation outcomes. The case emphasizes the importance of a comprehensive approach, including genetic testing, immunological assessment, endometrial evaluation, and patient counseling.
Abstract: This case study highlights the complex, multifactorial nature of recurrent implantation failure (RIF) in a young patient with a history of eight unsuccessful embryo transfers. It educates clinicians and embryologists on evidence-based strategies, potential diagnostic oversights, and treatment pathways that may improve implantation outcomes. The case emphasizes the importance of a comprehensive approach, including genetic testing, immunological assessment, endometrial evaluation, and patient counseling.

Patient Profile:
- Age: 34 years old
- History: 8 unsuccessful embryo transfers (4 Day 3 embryos, 4 Day 5 blastocysts)
- ERA: Normal receptive endometrium in natural cycle
- Lifestyle Factors: Nothing specific to mention
- BMI, Thyroid Function, Vitamin D Levels: All normal results
Embryo Quality:
- No documented PGT-A/PGS performed
- Morphology grading not specified
Treatment History:
Initial Attempts:
- 4 Day 3 embryos and 4 Day 5 blastocysts transferred with no implantation.
- ERA showed receptive endometrium in natural cycle.
Post-ERA Strategy:
- 2 FET cycles post-ERA.
- Minimal stimulation with Menopur 75IU every 2 days due to thin endometrium.
- Endometrial response adequate; hCG trigger + vaginal progesterone initiated on LH+3.
- Despite optimal thickness, no pregnancy was achieved.
Relevant Clinical Findings:
- Elevated anti-beta 2 glycoprotein IgG.
- Heparin and ASA were administered during FET cycles.
- Recent hysteroscopy: normal.
- Biopsy: polypoid endometrium, proliferative activity, ciliated/tubal metaplasia (no atypia).
Clinical Question: What are the underlying causes of this patient’s RIF, and what diagnostic and therapeutic steps should follow?

Expert Opinions summary:
- Expert Opinions Summary:
| Expert | Recommendations |
| Expert 1 | Maintain natural cycle protocol if ERA was natural; repeat ERA in HRT cycle (P+5); consider PGS for embryo quality. |
| Expert 2 | New stimulation with GnRH antagonist, rFSH + hMG; perform PGS; freeze all embryos for deferred transfer; perform karyotype of both partners. |
| Expert 3 | Recommend PGS; freeze all embryos; transfer euploid embryos in a natural cycle. |
- Consensus: Prioritize embryo genetic evaluation and reassess endometrial preparation method.
- .
Suggested Next Steps (Prioritized):
- Embryo Assessment:
- Perform PGT-A to evaluate chromosomal integrity.
- Consider comprehensive embryo quality assessment.
- Parental Karyotype Testing:
- Rule out balanced translocations or other chromosomal anomalies.
- Endometrial Evaluation:
- Consider endometrial scratching both in the follicular and luteal phase
- Consider hysteroscopic polypectomy if recurrent polypoid changes.
- Evaluate for chronic endometritis with CD138 immunostaining.
- Immunological Evaluation:
- Maintain anticoagulation therapy.
- Explore additional immunological markers and potential immunomodulation therapies.
- Emerging Therapies:
- Consider intrauterine PRP infusion.
- Patient Counseling:
- Discuss the multifactorial nature of RIF.
- Set realistic expectations for future attempts.
Conclusion: The patient exhibits recurrent implantation failure despite favorable ERA results and endometrial response after Menopur stimulation. Future strategies should prioritize embryo genetic evaluation, reassessing endometrial receptivity in a medicated cycle, and optimizing the immunological and structural endometrial environment to improve implantation chances.
Patient-Specific Risk Factor Table:
| Risk Factor Category | Patient Findings |
| Immunological | Elevated anti-beta 2 glycoprotein IgG |
| Endometrial | Polypoid endometrium, ciliated/tubal metaplasia |
| Embryonic | No PGT-A performed |
| Anatomical | Normal hysteroscopy |
| Thrombophilic | On heparin + ASA |
Literature Review Summary:
- RIF Overview: Affects ~5-10% of IVF patients (Li et al., 2024).
- Contributors to RIF: Maternal factors, embryo quality, immune factors, anatomical abnormalities, thrombophilia, male factors.
- Endometrial Receptivity: Thin endometrium (<7mm) and chronic endometritis reduce implantation rates (Anitua et al., 2023; Potiris et al., 2024).
- Immunological Impact: Antiphospholipid antibodies (Papadimitriou et al., 2022); immune imbalance can impair implantation (Kwak-Kim et al., 2014).
- Genetic Evaluation: Embryo aneuploidies common in RIF (Potiris et al., 2024).
- Emerging Therapies: Intrauterine PRP infusion shows promise (Farimani et al., 2017; Dawood et al., 2018).
Conclusion: This case exemplifies the complexity of RIF and the need for an individualized, multi-pronged approach. Next steps should prioritize embryo genetic testing, a thorough reassessment of endometrial receptivity, and enhanced immunological evaluation. Clinicians should also emphasize patient counseling to manage expectations and provide psychological support.

References
- Anitua E, Allende M, de la Fuente M, Del Fabbro M, Alkhraisat M. Efficacy of platelet-rich plasma in women with a history of embryo transfer failure: a systematic review and meta-analysis with trial sequential analysis. Bioengineering (Basel). 2023;10(3):303.
- Dawood A, Salem H. Current clinical applications of platelet-rich plasma in various gynecological disorders: an appraisal of theory and practice. Clin Exp Reprod Med. 2018;45(2):67–74.
- Farimani M, Poorolajal J, Rabiee S, Bahmanzadeh M. Successful pregnancy and live birth after intrauterine administration of autologous platelet-rich plasma in a woman with recurrent implantation failure: a case report. Int J Reprod Biomed. 2017;15(12):803–6.
- Fodina V, Dudorova A, Ērenpreiss J. Reasons and mechanisms of recurrent failed implantation in IVF. In: Infertility and Assisted Reproduction. London: IntechOpen; 2021.
- Kwak-Kim J, Bao S, Lee SK, Kim JW, Gilman-Sachs A. Immunological modes of pregnancy loss: inflammation, immune effectors, and stress. Am J Reprod Immunol. 2014;72(2):129–40.
- Li N, Zhang Y, Li R, Chen Y, Huang L, Tan Z, Ban X, Zhou L, Xu C, Qiu Y, Li R. Personalized embryo transfer guided by rsERT improves pregnancy outcomes in patients with repeated implantation failure. Front Med (Lausanne). 2024; 15;11:1369317
- Papadimitriou E, Boutzios G, Mathioudakis AG, Vlahos N, Vlachoyiannopoulos P, Mastorakos G. Presence of antiphospholipid antibodies is associated with increased implantation failure following in vitro fertilization technique and embryo transfer: a systematic review and meta-analysis. PLoS One. 2022;17(7):e0260759.
- Potiris A, Alyfanti E, Drakaki E, Mavrogianni D, Karampitsakos T, Machairoudias P, et al. The contribution of proteomics in understanding endometrial protein expression in women with recurrent implantation failure. J Clin Med. 2024;13(7):2145.
biweekly insights


